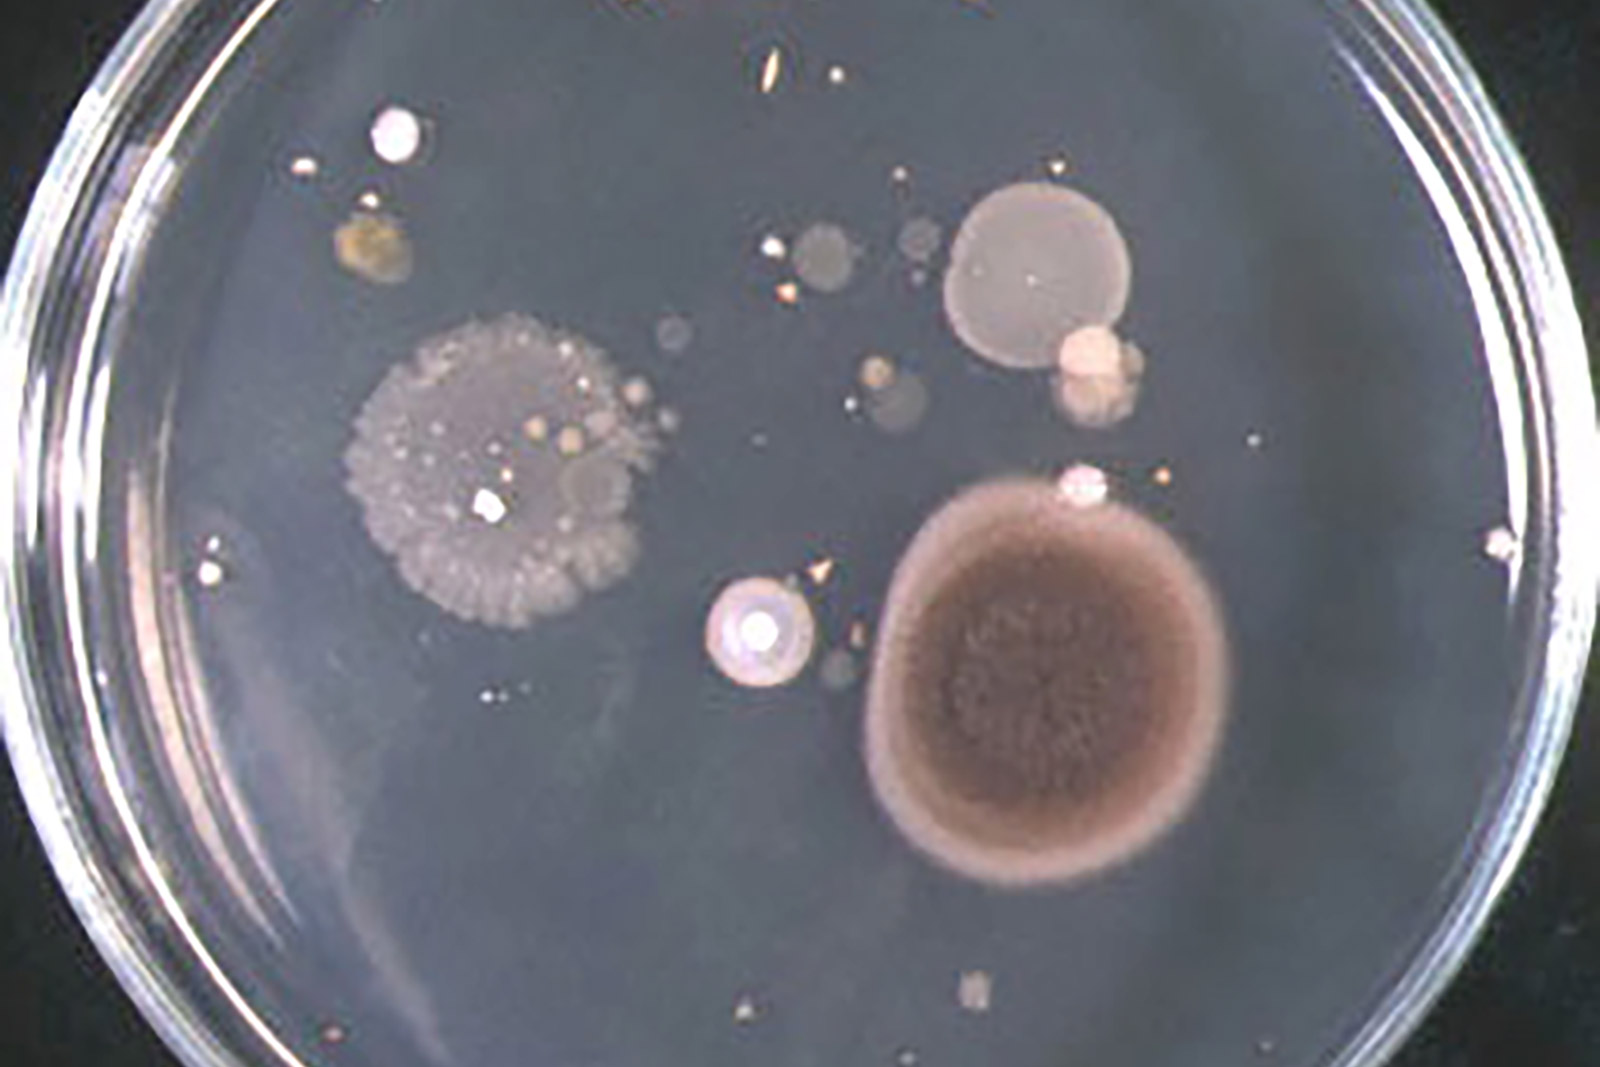

Compass 様々な専門家が語る明日の針路。
乳酸菌と土壌微生物の共通点。
そもそも微生物って、なに?
微生物と聞いて、何を思い浮かべるだろうか。
乳酸菌? バクテリア? プランクトン?
知っているようでよく分からない微生物の種類や働き。土壌微生物となるとさらに遠い存在だ。しかし、土壌微生物こそ生物多様性の根底に位置するものであり、地球上の生物を支える大切な存在なのだ。従って、土壌微生物を知れば生物多様性の本質が見えてくるはずだ。

私たちの暮らし、微生物なしでは語れない。味噌、醤油、納豆、酢、チーズ、ヨーグルト、日本酒などすべてが発酵食品。多くの身近な食べ物が微生物と関わりがあることは誰もが認識している。土の中にも微生物は多く棲んでいて、植物の生育を支え、豊かな土壌が豊かな実りをもたらすことも広く知られている。
しかしながら、微生物とは何かと問われると、具体的に説明できる人は多くはないだろう。佐賀大学名誉教授で土壌微生物学者でもある染谷孝先生さんに、身近な存在にも関わらず知らないことばかりの微生物について教えていただいた。
「微生物とは目に見えない小さな生きもの(※1)の総称です。大きく分けて細菌(バクテリア)と古細菌(アーキア)が属する原核生物(※2)と菌類、原生動物、藻類の3つが属する真核生物に分かれます。生物と非生物の中間にはウイルスがいます。私たちの生活は微生物と関わりのあるもので満ち溢れているのです」

順番に説明していこう。
原核生物に属するものは、細菌と古細菌だ。
細菌という言葉だけを聞くと大腸菌などの病原菌を思い浮かべ、良いイメージを感じないかもしれないが、細菌には乳酸菌などの身近な発酵微生物も含まれている。土壌中にも多種多様な細菌が生息していて、土づくりや環境浄化などに貢献している。多くの細菌は有機物を栄養源にして暮らしているが、中には水素ガスや鉄、硫黄、アンモニアなどを栄養源にする細菌や、有毒な硫化水素を作る硫酸還元菌、光合成をして暮らすシアノバクテリアなどもいる。
同じく原核生物である古細菌は、温泉に住む超好熱菌などの微生物が代表的だ。バイオガス施設で生ごみや屎尿からメタンガスを作るメタン生成菌も古細菌で、最近、さまざまな働きをするものが土壌や海洋に広く生息していることが分かってきている。
真核生物に属するものは菌類、原生動物、藻類の3種類だ。
菌類にはキノコやカビ、酵母菌が含まれる。つまりシイタケやマツタケなども菌類なのだ。シイタケのような菌類は腐生菌類といって、枯れ木を栄養にして育つ。オガクズなどで人工栽培できるため私たちの身近な食材になっている。一方、マツタケのように植物と共生して暮らす共生菌類は、植物の生育を陰ながら支えている。共生していないと発育できないため人工栽培は容易にできない。
菌類と同様に真核生物に属する原生動物とは、単細胞で暮らす動物のこと。ゾウリムシ(繊毛虫)やアメーバといえば、イメージしやすいだろう。これらは細菌などを捕食して栄養源にしている。
藻類は単細胞で暮らす植物だ。光合成をして栄養を作り出す。ケイ藻やクロレラなどの植物プランクトンが藻類である。
そして、ウイルス。
遺伝子とそれを包むタンパク質から出来ている生物と非生物の中間的存在で、自分では増殖できないので他の生物(動物、植物、細菌)の細胞に侵入して、その生物の働きを借りて増え、最後に細胞を破って外に飛び出す。インフルエンザウイルス、新型コロナウイルスなどヒトに重大な危害をもたらすウイルスもある。

原核生物と真核生物、そしてウイルス。微生物は種類も働きも実に多様だ。そして、私たちの周りには驚くほど多くの微生物が存在している。微生物についてはまだ解明されていないことも多いそうだが、近年、研究が進み私たちに有用な微生物の存在もわかってきている。
中でも身近なのは乳酸菌だ。乳酸菌は糖類を栄養源にして乳酸を作る微生物(細菌)で、ヨーグルト、チーズ、漬物、清酒などの発酵に利用されている。ヒトの健康にも重要な働きをしており、腸管内(小腸下部から大腸上部)に棲み着いて乳酸を出すことで酸に弱い病原菌の発育を抑える。またビタミン類を生産し免疫機能を活発にすることも明らかになってきた。
乳酸菌同様に日本人にとって身近な存在なのが酵母菌である。ビールやワイン、日本酒などの発酵酒は酵母菌によって作られている。ワインのふくよかな香りや日本酒の吟醸香は、酵母菌が作っている。ちなみに日本酒は酵母菌の他にもコウジカビと乳酸菌が協働して造られる。3種類の微生物を駆使して造られる日本酒は、世界でも珍しい高度な製法による発酵酒なのだそうだ。

私たちの健康や暮らしを支える乳酸菌。腸内を弱酸性に保ち、悪玉菌の増殖を抑えてくれる整腸効果のある微生物として注目している人も多いだろう。染谷先生によると、乳酸菌を主とする腸内細菌への考え方と土壌微生物に対する考え方には共通点があるという。
「病気や怪我の際に強い抗生物質を使うと乳酸菌をはじめとする腸内細菌が激減してしまいます。腸内細菌の重要性が広く知られていなかった時代は、良かれと思って使用した抗生物質によって体調を崩す人もいたようです。日本の農業でも、かつて同様なことがありました。植物病原菌に対抗するため強い農薬を大量に撒いたことで、土壌微生物が激減。その結果、土壌環境が悪化して植物病原菌が広がり、さらに強い農薬を必要とし、土はますます痩せ、作物は農薬まみれになっていったのです」
抗生物質と農薬。どちらも適量であれば問題ないのだが、過剰に使用すれば微生物の働きを弱め、結果として環境バランスを壊してしまうことになる。現在では微生物の働きが広く知られるようになり、腸内においても、土壌においても、微生物を全滅させるような方法を行うことは少なくなったと思われる。しかし乳酸菌などの身近な微生物に比べると、土壌微生物への関心はまだ低いのが現実だ。
生物多様性の本質を理解するためにも、土壌微生物の働きを知ることには大きな意味があると染谷先生さんは「土壌微生物は地球上の多様な生命を育む根底を成すものです。森林においても、農地においても、海洋においても(※3)、土壌微生物が生命を育む背景にいることは確かです。土壌微生物の世界が多様で安定しているからこそ、その先に多くの生命が存在できるのです。近年の環境変化と共に生物多様性のあり方が注目されていますが、生物多様性を考える際は、土壌微生物の存在にもっと関心を寄せて欲しいと思っています」と微生物の存在価値を表した。
生物多様性については、およそ目に見える動植物について論じられることが残念ながら多い。だが、目に見えない土壌微生物とその働きを知れば、目に見える動植物の生態に土壌微生物が大きく関係していることが理解できる。
染谷先生には、生物多様性を支える土壌微生物の驚くべき世界について、改めて教えていただくこととした。

- 染谷孝
- 佐賀大学農学部教授を経て2019年定年退職ののち名誉教授として研究に携わる。
専門は、土壌微生物学・環境微生物学。
※1:例外的に目に見える大きな微生物もいる
※2:真核生物は細胞核をもち、原核生物は細胞核をもたない。真核生物は遺伝子情報をもった核酸が核膜の中にあり、原核生物では細胞内にそのまま存在する。人や動植物、酵母などは真核生物、細菌は原核生物となる。(農林水産省HP参照)
※3:海洋生物の食料となる植物プランクトンは、主に陸地から流れてくる栄養分に頼っている。その栄養分とは多様な土壌微生物が暮らす土壌が育んだものである。
画像提供:染谷孝(佐賀大学名誉教授)
取材編集:帆足泰子










